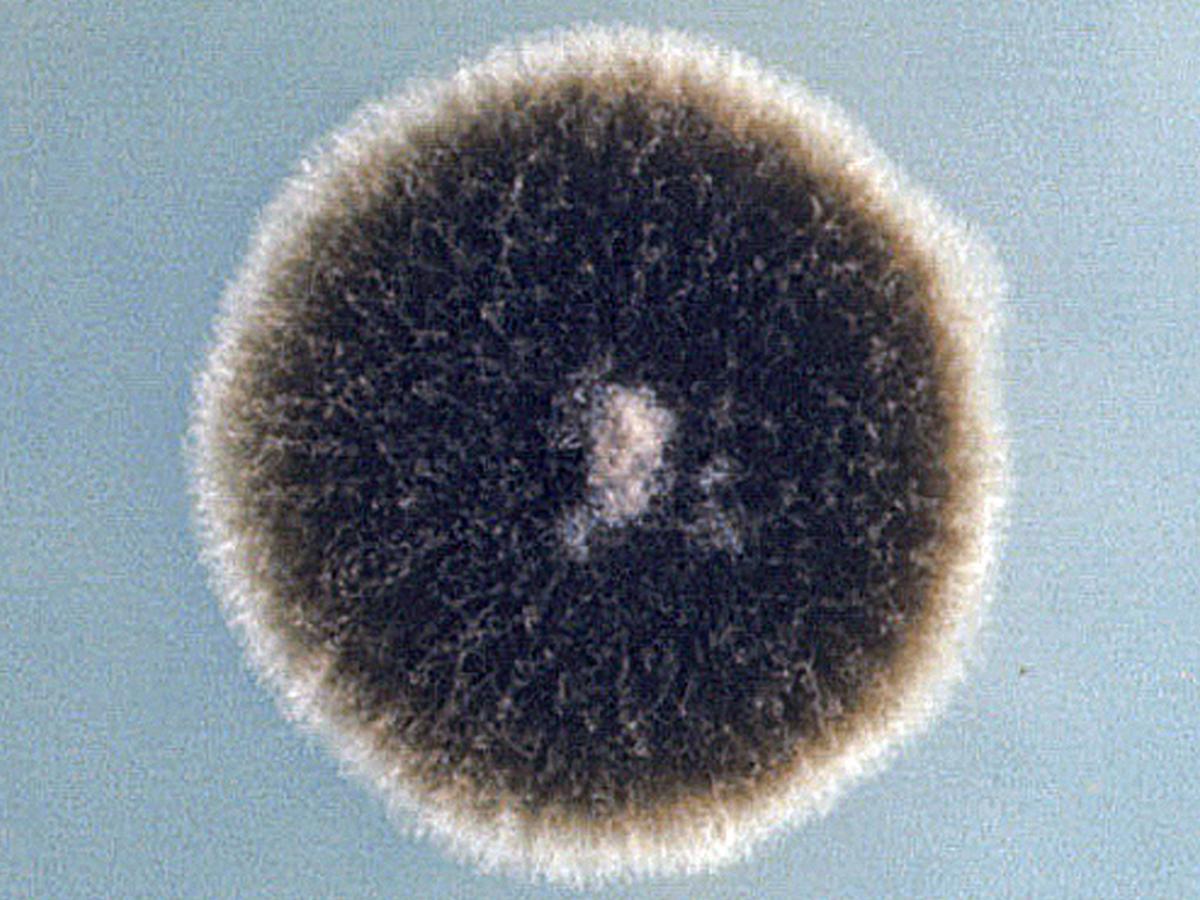
Alternaria_alternata.jpg
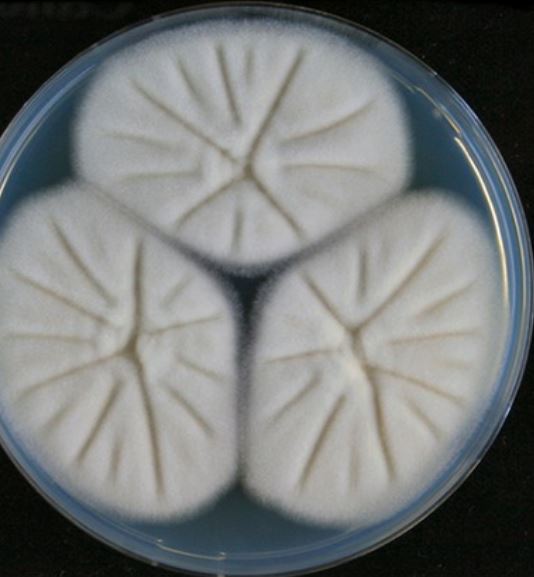
Aspergillus felis-2
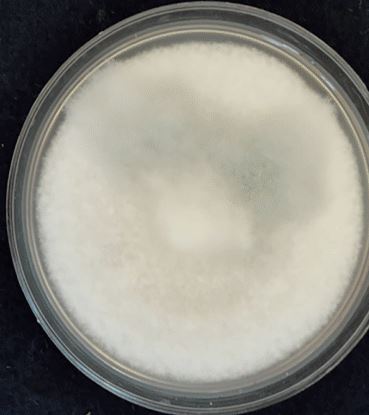
Aspergillus fischeri-2
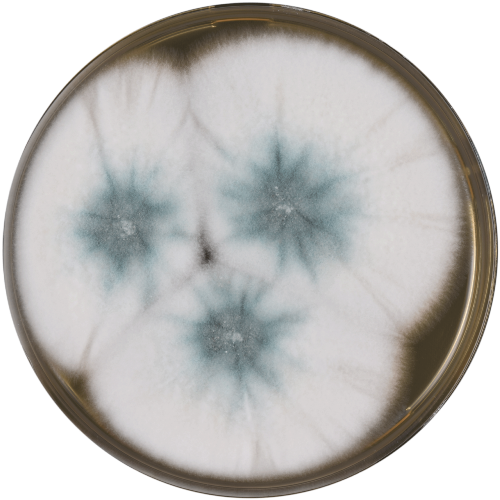
Aspergillus_lentulus-2.png
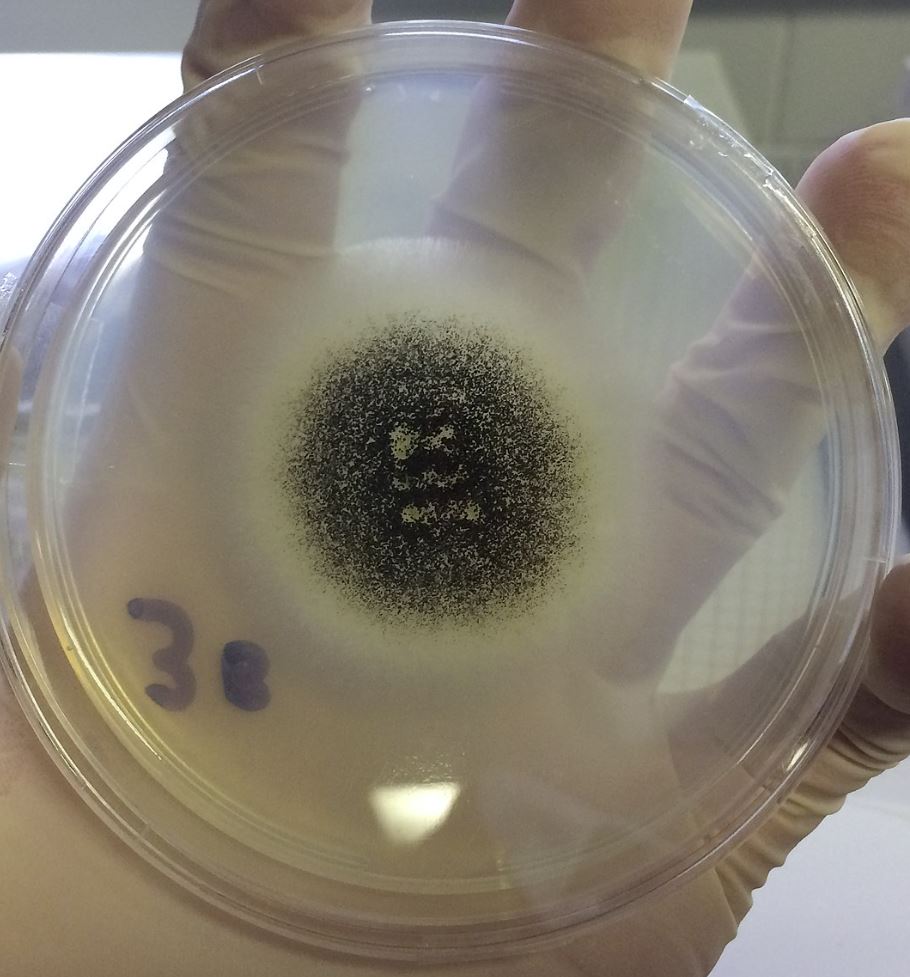
Aspergillus niger
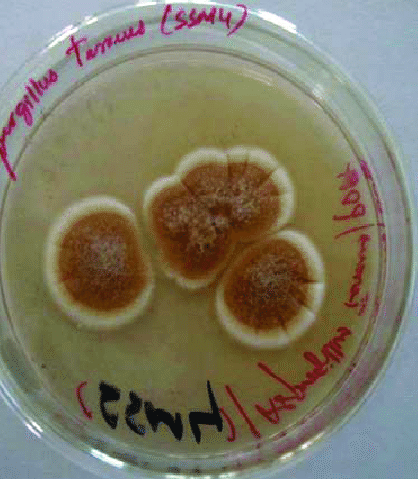
Aspergillus_terreus-2.png
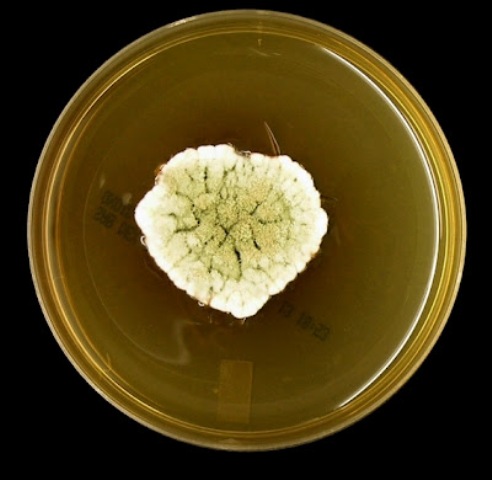
Aspergillus_versicolor.jpg
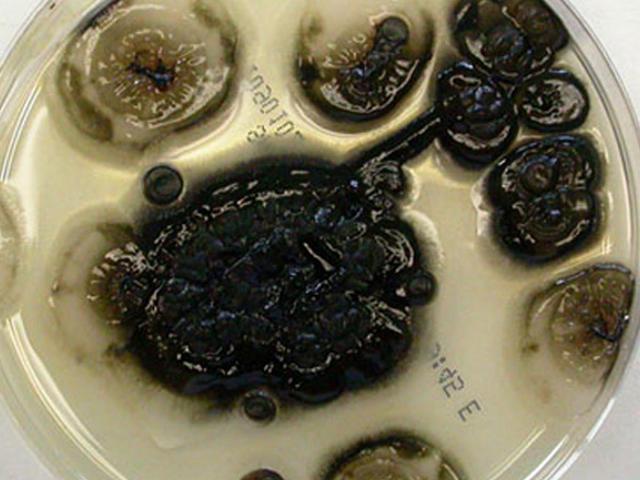
Aureobasidium_pullulans.jpg
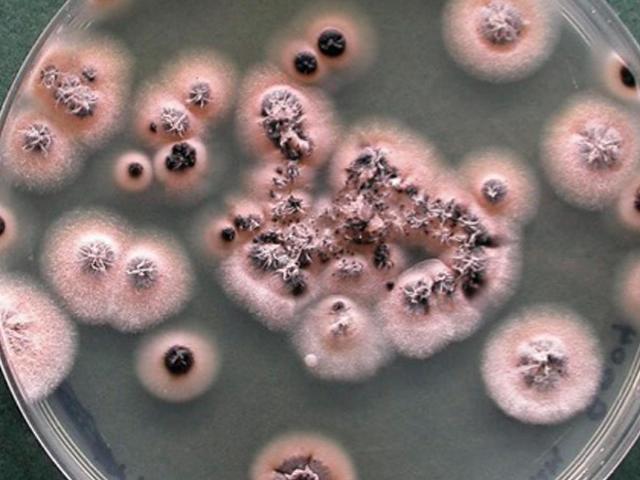
Coniochaeta_hoffmannii.jpg
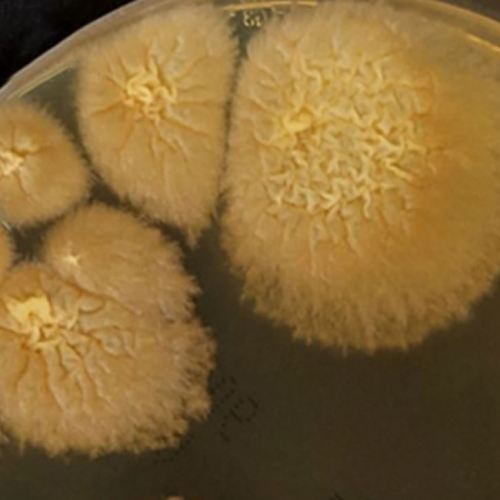
Coniochaeta hoffmannii-2
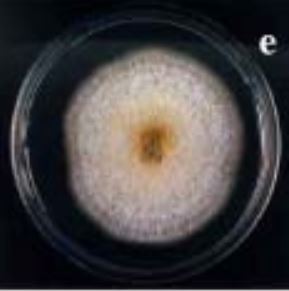
Cylindrocarpon-2
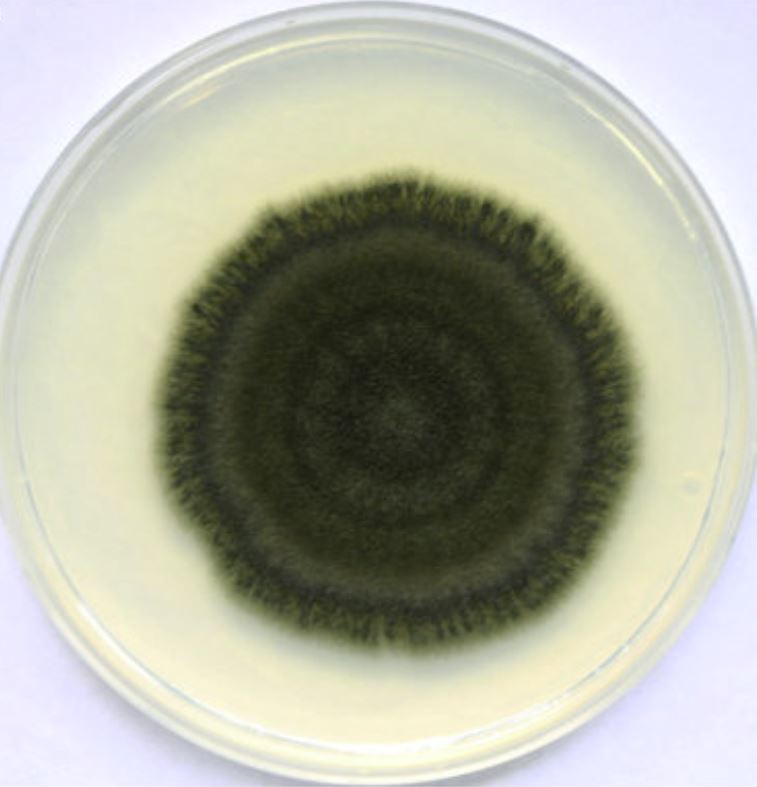
Curvularia-1
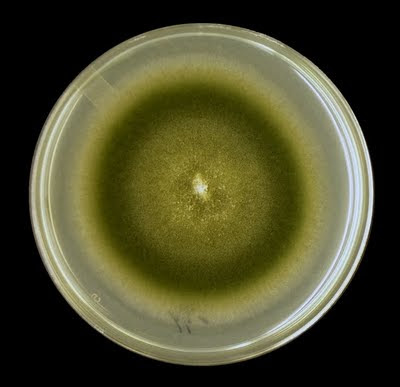
Curvularia-2
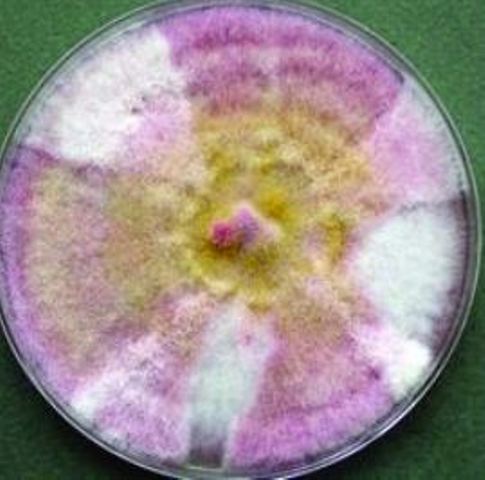
Fusarium Chlamydosporum
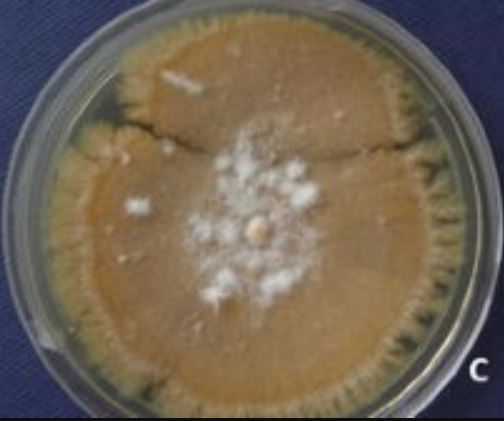
Fusarium_dimerum.jpg
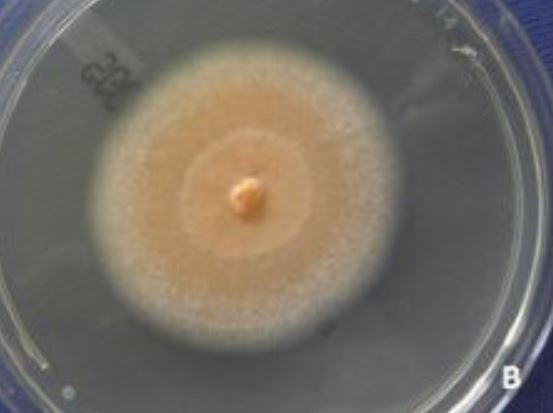
Seconda immagine Fusarium dimerum &ndash; fialidi rigonfie corti su piastra di coltura
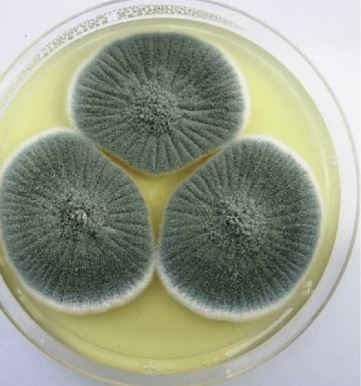
Colonia di Penicillium crustosum &ndash; bianca o verde opaco polverosa con conidi robusti
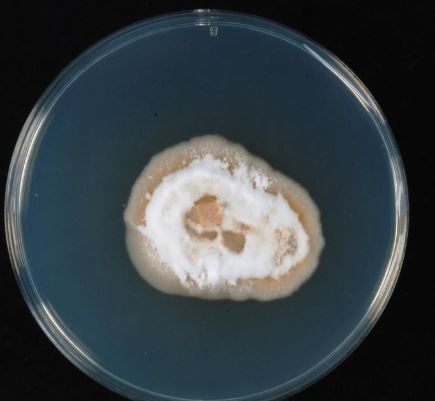
Sarocladium strictum-2
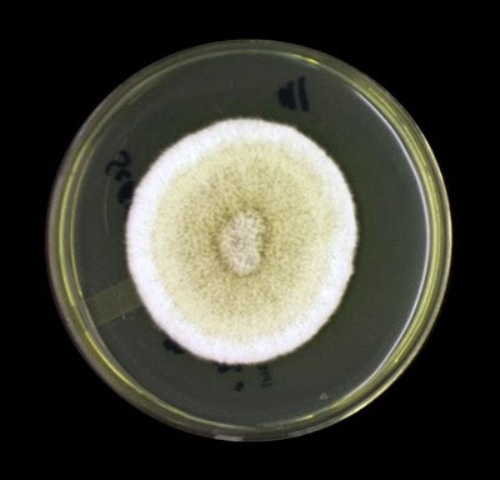
Scedosporium_apiospermum.jpg
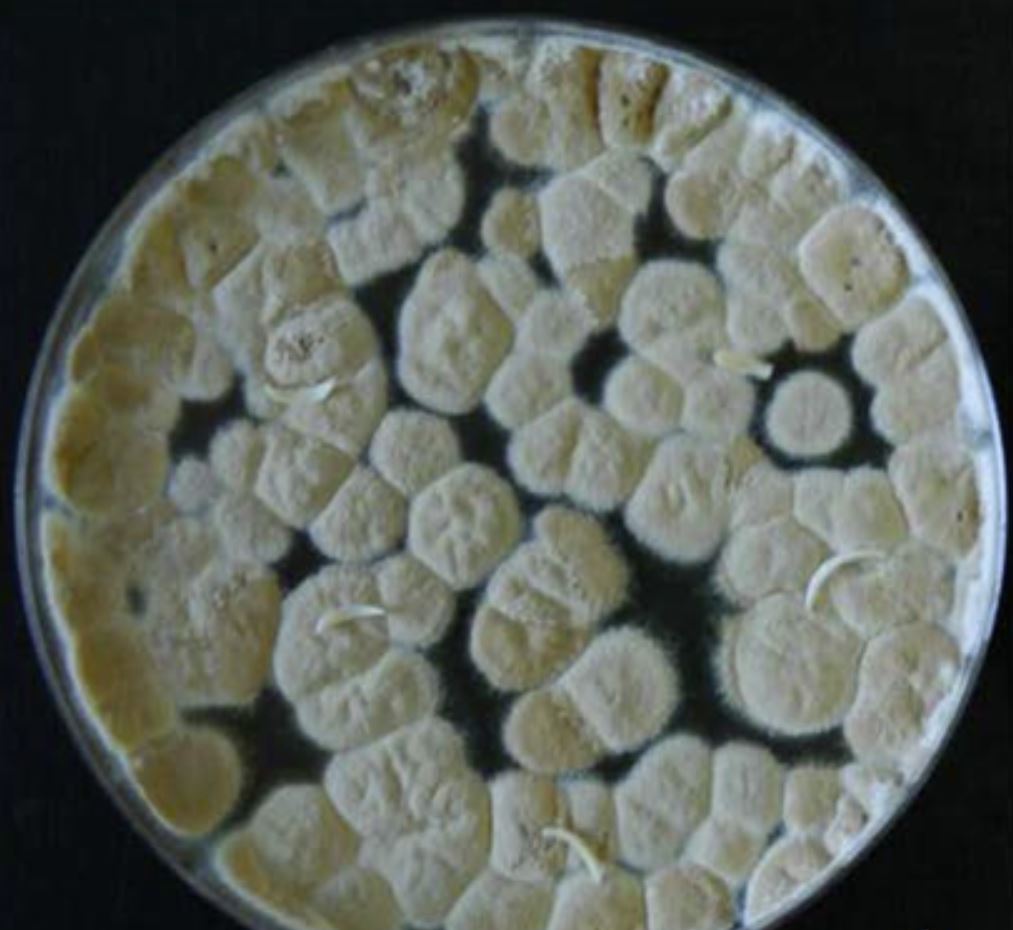
Scopulariopsis-2
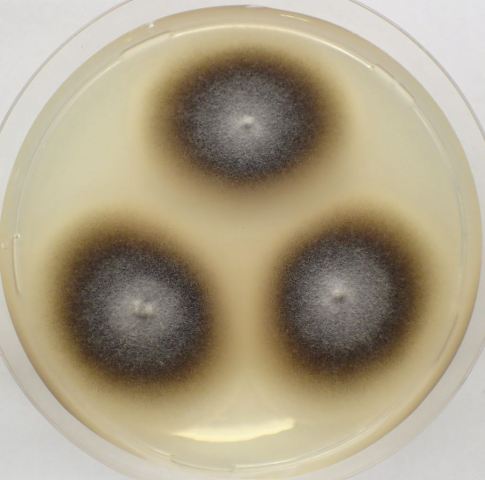
Stachybotrys chartarum
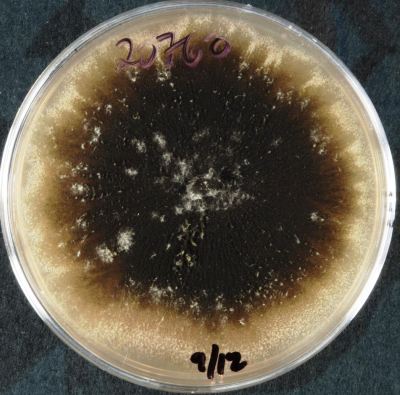
Stachybotrys chartarum-2
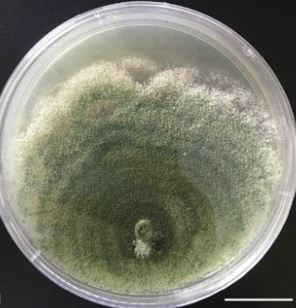
Trichoderma-2
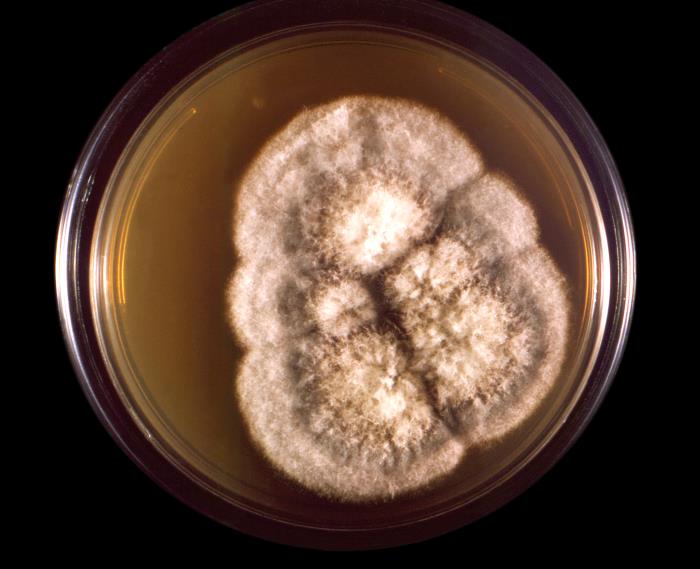
Coccidioides_immitis.jpg
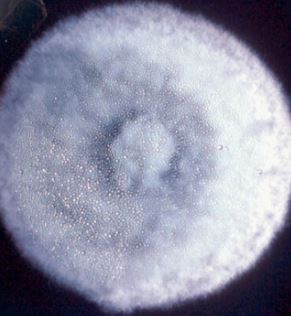
Coccidioides immitis-2
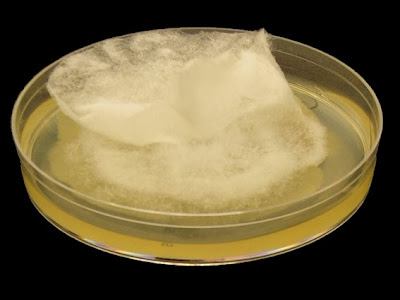
Apophomyces_variabilis_-2.jpg
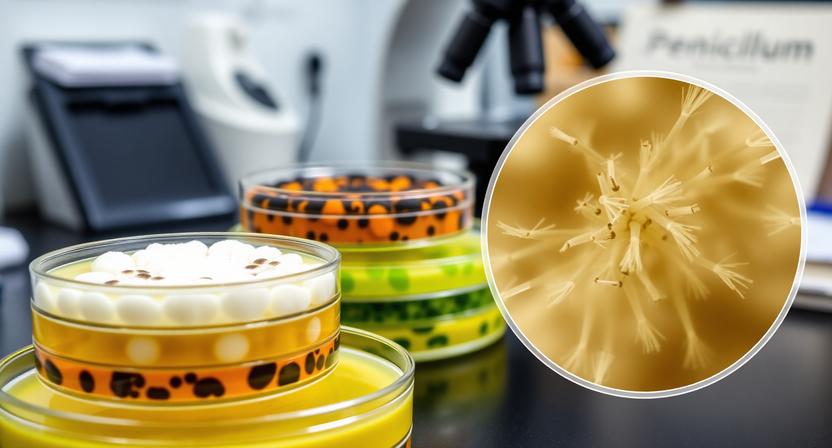
Atlante delle muffe

Un atlante delle muffe è un'opera di riferimento che fornisce una raccolta sistematica di informazioni sulle muffe. Lo scopo è divulgativo e può essere di aiuto a professionisti nel campo della microbiologia, dell'igiene ambientale e della sicurezza ambientale. Abbiamo avuto necessità di creare questa pagina perchè purtroppo su internet non esiste nulla di simile. Ciò va nell'ottica della tutela dalle minacce invisibili, che vede l'A2C impegnata dal 2008 ed in particolare nell'ambito del miglioramento della qualità dell'aria. L'identificazione accurata delle muffe è essenziale per adottare misure correttive adeguate e per garantire la sicurezza e la salute delle persone coinvolte. Inoltre può essere molto utile per la ricerca del miglior biocida collegato alla specie di muffa. Per ogni specie sono state prese di riferimento 2 foto, poichè spesso si riscontrano delle variabilità soprattutto in relazione al tipo di terreno utilizzato per la crescita e anche in relazione al numero di giorni di incubazione. Quando disponibile almeno 1 foto è relativa al terreno Sabouraud Agar (fondo tendente al giallino). Le immagini riportate sono state raccolte, tramite internet, da centri di ricerca internazionali attendibili.
![Schema di un conidio fungino con struttura conidioforo e vescicola]() Glossario essenziale:
Glossario essenziale:
-
Muffe: sono un tipo di organismi pluricellulari appartenenti al regno dei funghi. Sono capaci di ricoprire le superfici sotto forma di spugnosi miceli e solitamente si riproducono per mezzo di spore. Nella tassonomia e nella filogenesi le muffe non costituiscono un gruppo preciso, trovandosi nelle divisioni Zygomycota, Deuteromycota e Ascomycota.
-
Micelio: è l'apparato vegetativo della muffa ed è formato da un intreccio di filamenti detti ife. La massa miceliare si presenta in varie forme e colori a seconda della specie. Generalmente è uno strato schiumoso o filamentoso.
-
Ife: filamenti unicellulari o pluricellulari, di forma cilindrica allungati, che disposti uno sull'altro formano il micelio, ovvero il corpo vegetativo della muffa. Ad esempio negli zigomiceti le ife sono formate da un'unica cellula con più nuclei.
-
Conidioforo: è la parte di un'ifa fungina da cui si generano i conidi. Ad esempio, nel genere Aspergillus il conidioforo presenta alla sua sommità un ispessimento chiamato vescicola. Su di essa si forma la metula da cui si origina, a sua volta, la fialide dove sono i conidi. Nel genere Penicillium, nella parte superiore del conidioforo sono presenti ramificazioni multiple che tendono a diramarsi dicotomicamente e a formare un pennello (da cui il nome!).
- Conidi: sono spore utilizzate per la riproduzione asessuale. Il nome deriva dalla parola greca kónis, che significa polvere. Sono prodotti dai conidiofori, all'estremità delle ife fungine.
Per eventuali richieste di rimozione di foto scrivere a:
For any photo removal requests write to:
Ifomiceti — Hyphomycetes o muffe conidiali
Gli ifomiceti includono una grande varietà di stadi asessuali anamorfici e sono caratterizzati dalla produzione di spore asessuate esternamente al micelio. Alcuni di essi sono responsabili di malattie della pelle, delle unghie e del sistema pilifero; per questo motivo sono anche denominati dermatofiti. A differenza di quanto avviene nei Coelomycetes, i conidiofori non sono inseriti in un corpo fruttifero, ma sono sempre liberi; di solito sono isolati, ma a volte appaiono come fasci di cellule allineate in parallelo o come masse a forma di cuscino.
|
Alternaria alternata
Le colonie crescono rapidamente, da nere a nero-olivacee o grigiastre, da scamosciate a fioccose. Microscopicamente, le catene acropete ramificate (blastocatenato) dei conidi multicellulari (dictyoconidia) sono prodotte simpodialmente da conidiofori semplici, talvolta ramificati, corti o allungati. https://www.a2c.it/News-Patologia-Edile/lalternaria.html |
 |
 |
Aspergillus clavatus
Forma un feltro vellutato di colore blu-verdastro, spesso con un margine biancastro attorno ai bordi. Cresce in modo ottimale intorno ai 25°C, con una crescita minima a 5°C e massima vicino a 42°C. https://www.a2c.it/News-Patologia-Edile/laspergillus-clavatus.html |
 |
 |
Aspergillus felis
Le colonie sono da scamosciate a fioccose, bianche con macchie di conidi grigioverdi intervallate. Gli steli dei conidiofori hanno pareti lisce e le vescicole sono generalmente di forma subglobosa. Conidi globosi (2-3 µm di diametro), da lisci a finemente ruvidi. |
|
 |
Aspergillus fischeri
Le colonie sono da scamosciate a fioccose, da bianche a giallo pallido con conidiazione da lenta a scarsa. Gli steli dei conidiofori hanno pareti lisce e le vescicole sono generalmente da subglobose a forma di fiasco. Conidi da globosi a subglobosi (2-2,5 µm di diametro), da lisci a finemente ruvidi. Buona crescita a 37°C. |
|
 |
Aspergillus flavus
Le colonie sono granulari, piatte, spesso con solchi radiali, inizialmente gialle ma che diventano rapidamente da verde luminose a giallo-verdi scure con l'età. Le teste dei conidi sono tipicamente radiate, successivamente si dividono per formare colonne sciolte (per lo più 300-400 µm di diametro). https://www.a2c.it/News-Patologia-Edile/la-muffa-verde-sulle-pareti-aspergillus-flavus.html |
 |
 |
Aspergillus fumigatus
Le colonie sono tipicamente blu-verdi con una superficie simile alla pelle scamosciata costituita da un denso feltro di conidiofori. Le teste dei conidi sono tipicamente colonnari (fino a 400 x 50 µm ma spesso molto più corte e piccole) e uniseriate. https://www.a2c.it/News-Patologia-Edile/laspergillus-fumigatus.html |
 |
 |
Aspergillus glaucus
La colorazione delle colonie dipende dal terreno, ma è da verde opaco a verde intenso, fino a turchese grigiastro, con aree dal giallo all'arancione dove vengono prodotti i cleistoteci. Il rovescio va dal giallo pallido al giallo. La crescita è da lenta a moderata e matura in circa 7-21 giorni. |
 |
 |
Aspergillus lentulus
Le colonie sono da scamosciate a fioccose, bianche con macchie grigio-verdi intervallate da conidi (la conidiazione è da lenta a scarsa nella maggior parte dei ceppi). Le vescicole sono generalmente di forma subglobosa. Conidi da globosi a largamente ellissoidali (2-3,2 µm di diametro), da lisci a finemente ruvidi. |
|
|
Aspergillus niger
Le colonie sono costituite da un feltro basale compatto bianco o giallo ricoperto da uno strato denso di teste conidi dal marrone scuro al nero. Le teste dei conidi sono grandi (fino a 3 mm per 15-20 µm di diametro), globose, bruno scuro, diventano radiate e tendono a dividersi in numerose colonne sciolte con l'età. I conidi sono da globosi a subglobosi (3,5-5 µm di diametro), da marrone scuro a nero e con pareti ruvide. https://www.a2c.it/News-Patologia-Edile/la-muffa-nera-aspergillus-niger.html |
 |
|
Aspergillus terreus
Le colonie sono tipicamente scamosciate e di colore da marrone cannella a marrone sabbia con un rovescio da giallo a marrone sporco intenso. Le teste dei conidi sono compatte, colonnari (fino a 500 x 30-50 µm di diametro) e biseriate. I conidi sono da globosi a ellissoidali (1,5-2,5 µm di diametro), da ialini a leggermente gialli e con pareti lisce. |
 |
 |
Aspergillus unguis
Le colonie sono a crescita moderatamente rapida, piatte, di colore da bianco a marrone chiaro o beige, spesso con una consistenza superficiale polverosa o granulare. Pigmento inverso assente o giallo-brunastro chiaro con l'età. I conidi ialini e unicellulari sono prodotti direttamente sulle ife vegetative da cellule conidiogene non specializzate. |
 |
|
Aspergillus versicolor
Le colonie possono sviluppare una varietà di colori (da cui il nome "versicolor"). La struttura della colonia è simile alla pelle scamosciata, spesso con scanalature radiali. Il colore varia dal verde pallido, beige verdastro, verde grigio, verde rosato, verde salmone al verde scuro con sfumature malva o turchese. L'espansione della colonia è piuttosto lenta. La crescita è limitata a 35°C. https://www.a2c.it/News-Patologia-Edile/la-muffa-con-diverse-sfumature-di-colore-aspergillus-versicolor.html |
 |
|
Aureobasidium pullulans
Le colonie sono a crescita rapida, lisce, presto ricoperte da masse viscide di conidi, di colore crema o rosa, che successivamente diventano marroni o nere. Le ife sono ialine e settate, spesso diventano marrone scuro con l'età e formano catene di artroconidi da una a due cellule, con pareti spesse e pigmentati scuri. https://www.a2c.it/News-Patologia-Edile/aureobasidium-pullulans.html |
 |
 |
Chrysosporium
Le colonie sono a crescita moderatamente rapida, piatte, di colore da bianco a marrone chiaro o beige, spesso con una consistenza superficiale polverosa o granulare. Pigmento inverso assente o giallo-brunastro chiaro con l'età. I conidi ialini e unicellulari sono prodotti direttamente sulle ife vegetative da cellule conidiogene non specializzate. |
 |
 |
Cladophialophora bantiana
Le colonie sono a crescita moderatamente veloce, di colore grigio-olivaceo, da scamosciate a fioccose e crescono a temperature fino a 42-40°C. I conidi sono formati in lunghe catene acropete, scarsamente ramificate, flessuose da conidiofori indifferenziati. I conidi sono unicellulari (molto occasionalmente bicellulari), marrone chiaro, con pareti lisce, da ellissoidali a oblungo-ellissoidali e misurano 2-3 x 4-7 µm. |
 |
 |
Cladosporium cladosporioides
Le colonie sono a crescita lenta, per lo più da bruno-olivaceo a bruno-nerastro ma talvolta anche grigie, lucide o brune, da scamosciate a fioccose, spesso diventano polverose a causa della produzione di abbondanti conidi. Il rovescio è nero-olivaceo. Ife vegetative, conidiofori e conidi sono ugualmente pigmentati. I conidiofori sono più o meno distinti dalle ife vegetative. https://www.a2c.it/News-Patologia-Edile/cladosporium-cladosporioides.html |
 |
|
Coniochaeta hoffmannii
Le colonie sono piatte, lisce, umide, di colore dal rosa all'arancione, con margine regolare e netto; rosa inverso. Le ife sono strette, ialine, producono conidi lateralmente da piccoli collaretti direttamente sulle ife, o da cellule laterali che talvolta sono disposte in gruppi densi; cellule laterali a forma di fiasco o quasi cilindriche. |
|
 |
Cylindrocarpon
Le colonie sono a crescita rapida, ialine o di colore brillante, scamosciate o lanose. Occasionalmente può essere presente sporodochia. I conidiofori sono costituiti da fialidi semplici o ripetutamente verticillati, disposti in strutture a pennello. Le fialidi sono da cilindriche a subulate, con piccoli collaretti che producono conidi ialini, a pareti lisce, disposti in masse viscide. |
|
|
Curvularia
Le colonie crescono rapidamente, da scamosciate a lanuginose, da marroni a bruno nerastre con il rovescio nero. Conidiofori eretti, da diritti a flessuosi, settati, spesso genicolati (producendo conidi in successione simpodale) talvolta nodulosi. I conidi sono ellissoidali, spesso curvi o lunati, arrotondati alle estremità o talvolta si assottigliano leggermente verso la base, di colore marrone chiaro, da marrone rossastro medio a marrone scuro, 3-10 (solitamente 3-5) setti, parete dei conidi da liscia a verrucosa. |
|
|
Fusarium chlamydosporum
Colonie a crescita rapida, con abbondante micelio aereo, di colore rosa intenso, rosso o ocraceo fino a brunastro; rosso carminio inverso o da marrone chiaro a marrone. Sporodochia arancione, color carne o ocraceo. Conidiofori sparsi sul micelio aereo, ramificati; sono presenti numerose cellule conidiogene poliblastiche. |
 |
|
Fusarium dimerum
Colonie a crescita lenta; superficie generalmente da arancione ad albicocca intenso a causa della confluenza della melma conidica; micelio aereo talvolta fioccoso e biancastro. Conidiofori poco ramificati, con fialidi corti, spesso rigonfie, 10-18 x 4-5 μm. |
|
 |
Fusarium oxysporum
Colonie a crescita rapida, 4,5 cm in quattro giorni, micelio aereo bianco, che diventa viola, con discreti sporodochi arancioni presenti in alcuni ceppi; invertire la ialinità in blu scuro o viola scuro. I conidiofori sono monofialidi laterali corti, singoli nel micelio aereo, successivamente disposti in grappoli densamente ramificati. https://www.a2c.it/News-Patologia-Edile/fusarium-oxysporum.html |
 |
 |
Lomentospora prolificans
Le colonie crescono rapidamente, sono piatte, diffuse, di colore da grigio oliva a nero e hanno una struttura superficiale da scamosciata a lanuginosa. I conidi sono portati in piccoli gruppi su caratteristici conidiofori rigonfi, a forma di fiasco, che si presentano singolarmente o in gruppi lungo le ife vegetative. |
 |
 |
Marquandomyces marquandii
Le colonie crescono rapidamente, da scamosciate a fioccose, di colore da vinoso pallido a viola, con il rovescio da giallo a giallo arancio. I conidiofori sono eretti, originano da ife sommerse, lunghe 50-300 µm, portanti spirali sciolte di rami e fialidi. Gli steli conidiofori sono larghi 2,5-3,0 µm, ialini e con pareti lisce. |
 |
 |
Paecilomyces variotii
Le colonie crescono rapidamente, da polverose a scamosciate, funicolose o trapuntate e di colore giallo-marrone o color sabbia. Conidiofori portanti rami densi, disposti verticillatamente, portanti fialidi. Le fialidi sono cilindriche o ellissoidali, si assottigliano bruscamente in un collo lungo e cilindrico. |
 |
 |
Penicillium citrinum
La tessitura superficiale va da vellutata a fioccosa (ciuffi lanosi di morbidi "peli"). La crescita coloniale appare solcata radialmente (solchi stretti e profondi o solchi radiali, simili ai raggi di una ruota). La colonia matura ha un colore centrale da grigio-turchese a grigio-arancio con una periferia bianca (bordo esterno). Vengono spesso prodotti essudati (estroliti) che appaiono come gocce di liquido sulla superficie della colonia. Questi possono apparire di colore chiaro, giallo pallido, bruno-rossastro. |
 |
 |
Penicillium chrysogenum
Le colonie, di 25–40 mm di diametro, hanno generalmente l'aspetto piano, basso e vellutato, occasionalmente ciuffato o granulare al centro. Le colonie vanno dal turchese grigiastro al verde opaco, talvolta con colore giallastro. La produzione di conidi è moderata. I conidi sono ellissoidali, lunghi 2,5–4,0 µm, con pareti lisce. Sono portati in colonne lunghe e irregolari, che si formano su conidiofori a forma di pennello. https://www.a2c.it/News-Patologia-Edile/penicillium-chrysogenum.html |
 |
|
Penicillium crustosum
Colonie solitamente di 20–40 mm di diametro, con una superficie piana o meno comunemente marcata radialmente. La tessitura superficiale può essere vellutata o granulare con aspetto polveroso. La colonia solitamente appare bianca o verde opaco a causa della forte produzione di conidi sull'intera area della colonia. Tutti gli elementi conidi sono robusti e grandi. |
 |
 |
Penicillium digitatum
Le spore germinate sono di colore giallo-verdastro o olivastro circondate da un piccolo cerchio di micelio bianco. Raggiunge la sua crescita ottimale a 24°C. Tipico odore di marciume umido. |
 |
 |
Purpureocillium lilacinum
Le colonie crescono velocemente, da scamosciate a fioccose, da vinaccia a violacee. I conidiofori sono eretti, lunghi 400-600 µm, e portano rami con fialidi densamente raggruppati. I gambi dei conidiofori sono larghi 3-4 µm, di colore da giallo a viola e con pareti ruvide. |
 |
 |
Sarocladium strictum
Colonie a crescita rapida, da umide a viscide, rosa o arancioni; il rovescio rimane incolore o vira dal rosa all'arancione. Conidiofori semplici, occasionalmente ramificati. Fialidi snelle, derivanti da ife aeree sommerse o leggermente fascicolate, 20-65 × 1,4-2,5 μm. |
|
|
Scedosporium apiospermum
Colonia a crescita moderatamente rapida a 25°C che matura in circa una settimana. La tessitura varia da lanosa a cotonosa. La colonia è bianca che diventa grigiastra o marrone in superficie; il rovescio è pallido con zone bruno-nere. Attenzione: gli stati conidi di S. apiospermum e S. boydii sono morfologicamente indistinguibili. |
 |
 |
Scopulariopsis brevicaulis
Le colonie crescono rapidamente, variano di colore dal bianco, crema, grigio, marrone chiaro al marrone e nero, ma sono prevalentemente marrone chiaro. La morfologia microscopica mostra catene di conidi unicellulari prodotti in successione basipeta da una cellula conidiogena specializzata chiamata anellide. I conidi sono da globosi a piriformi, generalmente troncati, con una porzione distale arrotondata, da liscia a ruvida e di colore da ialino a marrone. |
|
|
Stachybotrys chartarum
Le colonie mostrano una crescita rapida, maturando in tre o quattro giorni. Ha una consistenza da polverosa a cotonosa. La colorazione superficiale è inizialmente bianca ma diventa rapidamente nera, ma può anche presentare sulla superficie rosa o arancione a seconda del mezzo di crescita e della specie. Anche il retro è marrone scuro o nero. https://www.a2c.it/News-Patologia-Edile/la-muffa-nera-sulle-pareti-stachybotrys.html |
|
 |
Trichoderma
Le colonie crescono rapidamente, dapprima bianche e lanuginose, successivamente sviluppano cespi compatti dal verde giallastro al verde intenso, spesso solo in piccole aree o in zone concentriche ad anello sulla superficie dell'agar. I conidiofori sono ripetutamente ramificati, irregolarmente verticillati, portanti grappoli di fialidi divergenti, spesso irregolarmente piegati, a forma di fiasco. |
|
Funghi dimorfici (muffe-lieviti)
Il dimorfismo fungino è la capacità di alcune specie fungine di modificare reversibilmente la loro espressione morfologica, passando dalla forma filamentosa (muffa) a quella unicellulare (lievito) in base a variazioni ambientali, in particolar modo a variazioni della temperatura. Sono agenti patogeni fungini che possono superare le difese fisiologiche e cellulari del normale ospite umano modificando la loro forma morfologica. Le colture di questi funghi rappresentano un grave rischio biologico ed è necessaria una cabina di sicurezza biologica di Classe II.
 |
Blastomyces dermatitidis
Filamentoso. Crescita moderatamente lenta, di solito matura in circa 2 settimane, ma le colture sospette devono essere conservate per 8 settimane prima di essere scartate come negative. Presenta una consistenza cotonosa o lanuginosa. Le colonie producono ife areali bianche sulla superficie che possono assumere un colore da giallastro a marrone chiaro con l'invecchiamento della colonia. Il retro è tipicamente da marrone chiaro a marrone. |
 |
|
Coccidioides immitis
Cresce in coltura in 3-4 giorni, è inizialmente bianca o grigia ma dopo qualche settimana vira verso il marrone, si presenta glabra e sviluppa velocemente miceli aerei. Microscopicamente la muffa presenta ife settate ialine scarsamente ramificate che producono artroconidi cilindrici lunghi 3-5 µm e larghi 2-4 µm separati tra loro da cellule di giunzione. |
|
Coelomycetes
Classe di muffe conidiali in cui i conidi si formano all'interno di una cavità rivestita da tessuto fungino o ospite. Le strutture fruttifere possono essere sferiche con apertura apicale (picnidi) oppure a forma di piattino (acervuli). La produzione di conidi all'interno di un corpo fruttifero distingue questo gruppo dagli ifomiceti che hanno conidi "nudi".
 |
Neoscytalidium dimidiatum
Filamentoso. Produce ife sinuose e irregolari ed è caratterizzato da colonie a rapida crescita che sono profondamente ricoperte di micelio aereo denso, cordato, di colore scuro. Inizialmente di colore chiaro e diventano marrone scuro e poi nere con l'età. Sia gli artroconidi che i picnidi possono essere prodotti nella stessa coltura. |
 |
 |
Phoma glomerata
Colonie a crescita rapida che solitamente raggiungono la maturità entro cinque giorni. Consistenza vellutata, anche se alcune fonti aggiungono che possono apparire polverose o addirittura lanose. Le colonie sono solitamente descritte come di colore da marrone a olivaceo e persino grigio. Il rovescio va dal marrone al marrone scuro al nero con alcune specie che producono un pigmento diffusibile bruno-rossastro. |
 |
Zigomiceti (Zygomycota)
Costituiscono una divisione (o phylum) all'interno del regno dei funghi. Vengono così chiamati per la loro riproduzione sessuata che avviene tramite comparsa di strutture bulbose a forma di giogo. Come per tutti i funghi filamentosi, il corpo degli Zigomiceti è il micelio, un intreccio di ife, lunghi filamenti cellulari, che cresce nella materia morta o negli organismi parassitati.
 |
Apophysomyces variabilis
Crescita molto rapida, spesso riempie la capsula di Petri con abbondante micelio lanoso in due o tre giorni. La crescita appare inizialmente di colore bianco o biancastro, ma può acquisire un leggero colore grigio-brunastro con l'invecchiamento della colonia. Il rovescio va dal bianco al giallo pallido. |
|
 |
Mucor
Colonie a crescita rapida che riempiono una piastra di coltura nel giro di pochi giorni con una crescita lanosa che ricorda lo zucchero filato. La nuova crescita è di colore bianco ma diventa bruno-grigiastro con l'invecchiamento. Il rovescio rimane un bianco pallido. |
 |
 |
Mucor circinelloides
La crescita delle colonie è bassa e rada, e nella maggior parte dei casi si estende all'intera capsula Petri. Le colonie sono di solito di 60 mm di diametro o più e sembrano essere di colore grigio chiaro o giallo, mentre il rovescio è incolore. |
 |
 |
Rhizopus arrhizus
Colonie a crescita rapida che possono riempire una capsula di Petri con una crescita soffice, simile allo zucchero filato, in meno di 5 giorni. La crescita è generalmente di colore biancastro che può virare al marrone con l'età a causa della maturazione delle sporangiospore all'interno dello sporangio. |
 |
 |
Saksenaea
Una colonia soffice, simile ad una ragnatela, in rapida espansione. La crescita può riempire la capsula Petri entro 48 ore. Potrebbe verificarsi un sollevamento del coperchio se le piastre sono scarsamente sigillate. La colonia appare di colore da bianco sporco a grigiastro. |
 |
Lieviti simili a muffe
Recentemente sono stati effettuati numerosi riarrangiamenti tassonomici. Dal punto di vista dell'apparenza al microscopio si possono inquadrare e denominare alcuni basidiomiceti e ascomiceti nella categoria di lieviti simili a muffe.
 |
Rhodotorula
Le colonie sono rosa corallo, generalmente lisce, talvolta reticolate, rugose o ondulate, da umide a mucoidi, simili a lieviti. Cellule gemmanti simili a lieviti o blastoconidi da sferiche ad allungate, 2,5-6,5 x 6,5-14,0 µm; è un comune contaminante presente nell'aria della pelle, dei polmoni, delle urine e delle feci. |
 |
Per sapere come si svolge una diagnosi della patologia edile e cosa aspettarti dall'ispezione tecnica, consulta la pagina dedicata al servizio.
Hai trovato muffe in casa e non sai se sono pericolose?

Sospetti che la muffa in casa stia causando problemi di salute alla tua famiglia? L'unico modo per saperlo con certezza è un'indagine microbiologica: un tecnico viene direttamente a casa tua, effettua campionamenti sulle pareti e nell'aria, e in pochi giorni ricevi una relazione tecnica con l'identificazione precisa delle muffe presenti e la valutazione del rischio sanitario. Il servizio è eseguito con il supporto di laboratorio specializzato.
Indagine microbiologica specialistica: 500 €, tasse comprese.
Se invece vuoi partire dalla mappatura dell'umidità e delle anomalie con strumentazione professionale, è disponibile anche l'indagine strumentale di base a 300 €, tasse comprese.
Non sai da dove partire? Richiedi una valutazione visiva preliminare a 100 €, tasse comprese.
Prezzi riferiti ad appartamenti fino a 100 m², escluse eventuali spese di trasferta.
📍 Servizio attivo nelle province di Salerno e Avellino.
Il presente servizio è attivo esclusivamente nei seguenti comuni: Salerno, Cava de' Tirreni, Castiglione del Genovesi, Pellezzano, Vietri sul Mare, Baronissi, Fisciano, Pontecagnano Faiano, San Mango Piemonte, Cetara, Bellizzi, Nocera Inferiore, Mercato San Severino, Pagani, Battipaglia, Sant'Egidio del Monte Albino, Montoro Inferiore, Minori, Maiori, Corbara, Nocera Superiore, Eboli, Roccapiemonte, Angri, Atrani, Montecorvino Pugliano, Castel San Giorgio, Amalfi, San Valentino Torio, Solofra, San Marzano sul Sarno, Sarno, Bracigliano, Scafati, Pompei, Montoro Superiore, Siano, Sant'Antonio Abate, Santa Maria la Carità, Striano, Forino, Ravello, Gragnano, Poggiomarino, Torre Annunziata, San Cipriano Picentino, Scala, Lettere, Casola di Napoli, Praiano, Conca dei Marini, Tramonti, Serino, Castellammare di Stabia, San Giuseppe Vesuviano, Santo Stefano del Sole, Cesinali, Terzigno, Campagna, Palma Campania, Ottaviano, Aiello del Sabato, Trecase, Albanella, San Gennaro Vesuviano, Calvanico, Atripalda, Capriglia Irpina, Pimonte, Marigliano, Nola, San Paolo Bel Sito, Contursi Terme, Furore, Torre del Greco, Mariglianella, Avellino, Contrada, Vico Equense, Tufino, San Vitaliano, Scisciano, Comiziano, Saviano, Casamarciano, Camposano, San Sebastiano al Vesuvio, Somma Vesuviana, Brusciano, Palomonte, Portici, Cicciano, Acerno, Cercola, San Giorgio a Cremano, Sant'Anastasia, Pomigliano d'Arco, Oliveto Citra, Domicella, Colliano, Baiano, Montefalcione, Pratola Serra, Volla, Altavilla Silentina, Sicignano degli Alburni, Liveri, Castello di Cisterna, Polla, Agerola, Pollena Trocchia, Napoli, Cimitile, Avella, Acerra, Montefredane, San Michele di Serino, Monteforte Irpino, Mercogliano, Positano, Candida, Parolise, Lauro, Moschiano, Manocalzati, Olevano sul Tusciano, Quindici, Giffoni Valle Piana, Valva, Buccino, Giffoni Sei Casali, Visciano, Carbonara di Nola, Postiglione, Casavatore, Pertosa, Casoria, Sorbo Serpico, San Potito Ultra, Pago del Vallo di Lauro, Casalnuovo di Napoli, Romagnano al Monte, Auletta, Recale, Casagiove, San Nicola la Strada, Sant'Angelo a Scala, Marzano di Nola, Mugnano del Cardinale, Afragola, Arzano, Crispano, Casapulla, Meta, Grottolella, Ospedaletto d'Alpinolo, Taurano, Pietradefusi, Montemiletto, Capaccio, Castelcivita, Santomenna, Curti, San Prisco, Sirignano, Petina, Caserta, Capodrise, Trentinara, Torre Le Nocelle, Caivano, Cardito, Melito di Napoli, Sant'Arpino, Succivo, Sala Consilina, San Felice a Cancello, Santa Maria a Vico, Portico di Caserta, Piano di Sorrento, Montefusco, Roccarainola, Frattaminore, Frattamaggiore, Grumo Nevano, Cesa, Macerata Campania, Santa Maria Capua Vetere, San Rufo, Quadrelle, Aquara, Marcianise.
Domande frequenti sulle muffe in casa
Tutte le muffe trovate sulle pareti sono pericolose per la salute?
Non tutte le muffe sono ugualmente pericolose, ma nessuna presenza massiva va ignorata. Alcune specie come Stachybotrys chartarum o Aspergillus fumigatus producono micotossine o spore che irritano le vie respiratorie, soprattutto in bambini, anziani e soggetti allergici. Solo un'analisi microbiologica consente di identificare la specie e valutare il rischio reale.
Come faccio a capire quale tipo di muffa ho in casa senza un laboratorio?
Il colore e l'aspetto visivo danno indicazioni di massima — nero opaco per Stachybotrys, verde per Aspergillus o Penicillium, rosata per Fusarium — ma non sono sufficienti per una diagnosi certa. Specie diverse possono avere colorazioni simili a seconda del substrato e delle condizioni ambientali. Un campionamento con analisi in laboratorio è l'unico metodo affidabile.
Il biocida da supermercato è sufficiente per eliminare le muffe in casa?
I prodotti commerciali a base di ipoclorito di sodio possono rimuovere temporaneamente la muffa visibile, ma non eliminano il problema alla radice. Senza identificare la specie, la fonte di umidità e il substrato colonizzato, la muffa si ricostituisce entro poche settimane. Il biocida giusto dipende dalla specie: quello efficace su Cladosporium può non esserlo su Mucor o sugli zigomiceti.
Le muffe possono tornare anche dopo una bonifica professionale?
Sì, se non viene eliminata la causa dell'umidità. La bonifica tratta il sintomo, non la causa. Se persiste un ponte termico, una perdita occulta o una ventilazione insufficiente, le spore presenti nell'aria si depositano nuovamente e la colonia si riformerà. Una buona bonifica include sempre la diagnosi della sorgente di umidità e le indicazioni per correggerla strutturalmente.
Quando è necessario chiamare un tecnico invece di intervenire da soli?
È consigliato rivolgersi a un professionista quando la superficie colonizzata supera i 0,5 m², quando la muffa si trova su materiali porosi (intonaco, cartongesso, legno strutturale), quando ci sono bambini piccoli o persone immunodepresse in casa, o quando la presenza si ripete nonostante i trattamenti ripetuti. In questi casi un sopralluogo tecnico consente di individuare la causa e scegliere la strategia di intervento corretta.
Le muffe negli ambienti domestici sono un problema reale e misurabile. Identificarle correttamente è il primo passo per intervenire in modo efficace e duraturo.

Glossario essenziale:
Glossario essenziale:

